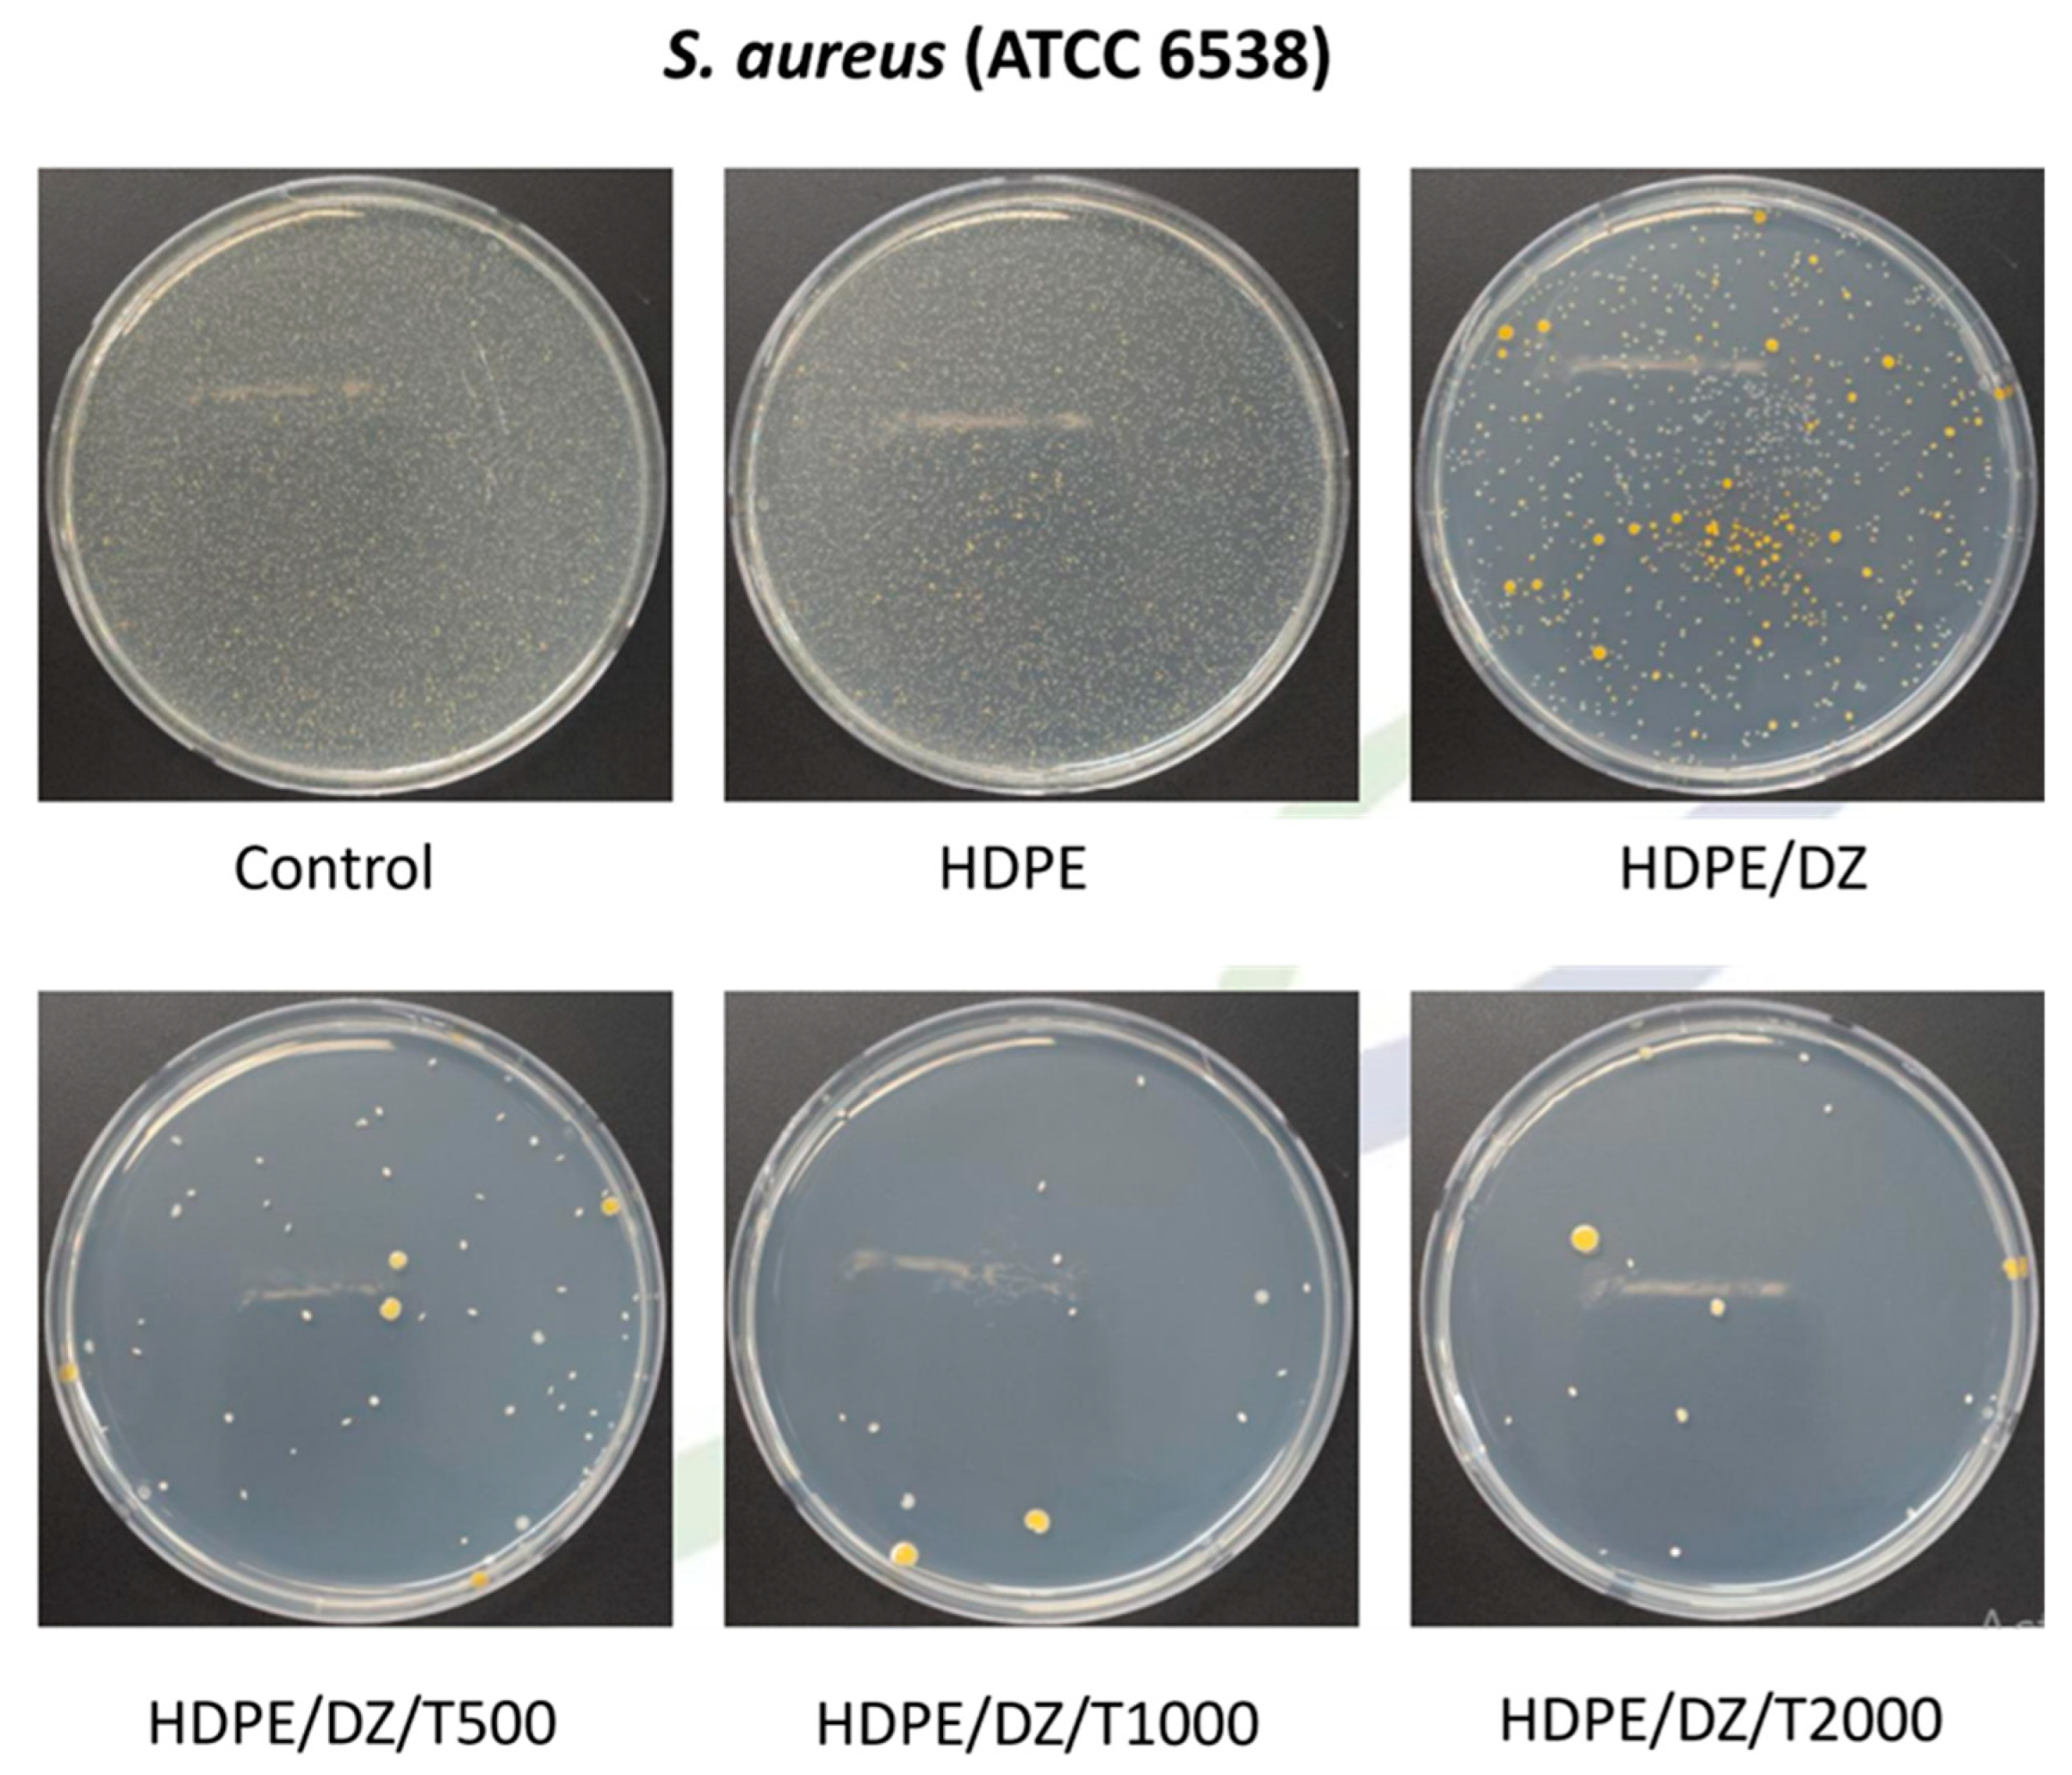
Polymers 15 04577 g006
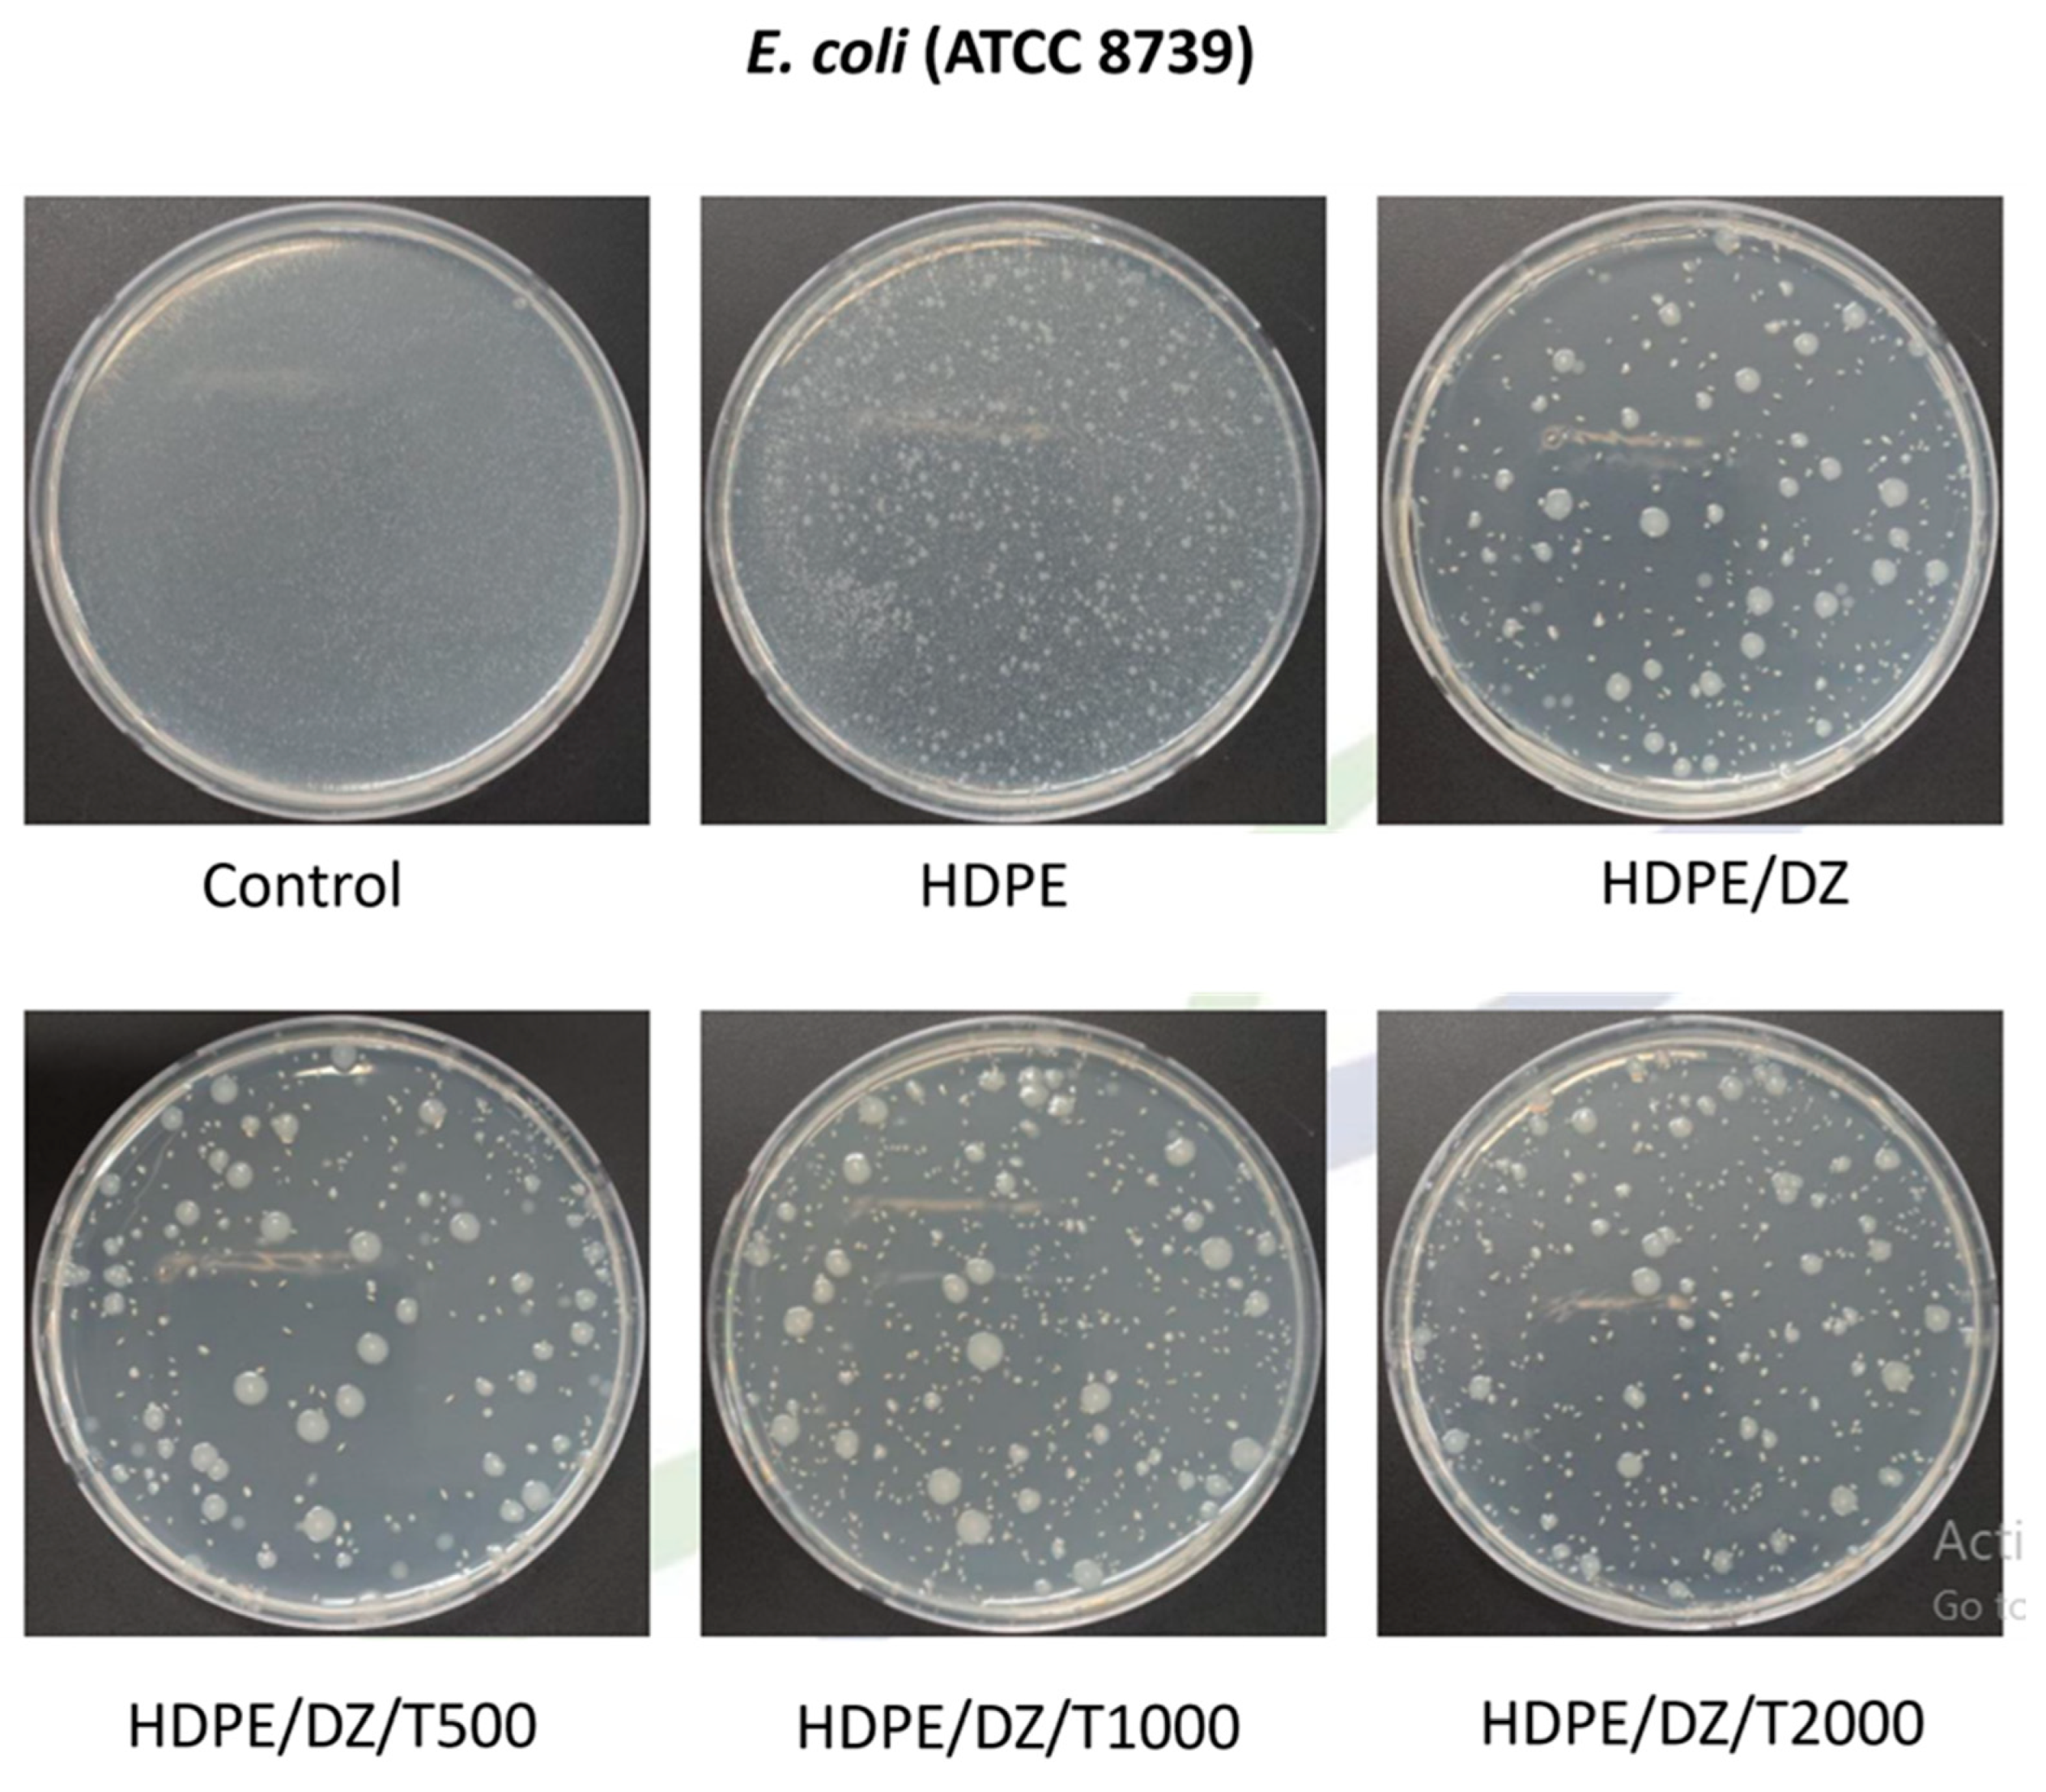
Polymers 15 04577 g007

Innovative HDPE Composites Enriched with UV Stabilizer and Diatomaceous Earth/Zinc Oxide for Enhanced Seafood Packaging and Antimicrobial Properties
Abstract
:1. Introduction
2. Materials and Methods
2.1. Materials
2.2. Preparation of Composite and Injection Molding
2.3. Characterization
2.4. UV Weathering Test
2.5. Antimicrobial Activity Assessment
2.6. Statistical Analysis
3. Results
3.1. Characterization
3.2. UV Weathering Test
3.3. Investigation of Antibacterial Properties in Injection-Molded Test Specimens
4. Conclusions
Author Contributions
Funding
Institutional Review Board Statement
Data Availability Statement
Acknowledgments
Conflicts of Interest
References
- Kontominas, M.G.; Badeka, A.V.; Kosma, I.S.; Nathanailides, C.I. Recent Developments in Seafood Packaging Technologies. Foods 2021, 10, 940. [Google Scholar] [CrossRef]
- Mexis, S.; Kontominas, M. Packaging|Active food packaging. In Encyclopedia of Food Microbiology, 2nd ed.; Batt, C.A., Tortorello, M.L., Eds.; Academic Press: Cambridge, MA, USA, 2014; pp. 999–1005. [Google Scholar]
- Humaid, S.; Nayyar, D.; Bolton, J.; Skonberg, D.I. Physicochemical Properties and Consumer Acceptance of High-Pressure Processed, Sous Vide-Cooked Lobster Tails. J. Food Sci. 2019, 84, 3454–3462. [Google Scholar] [CrossRef]
- Olatunde, O.O.; Benjakul, S. Antioxidants from Crustaceans: A Panacea for Lipid Oxidation in Marine-Based Foods. Food Rev. Int. 2022, 38, 1–31. [Google Scholar] [CrossRef]
- Hussain, M.A.; Sumon, T.A.; Mazumder, S.K.; Ali, M.M.; Jang, W.J.; Abualreesh, M.H.; Sharifuzzaman, S.M.; Brown, C.L.; Lee, H.-T.; Lee, E.-W.; et al. Essential oils and chitosan as alternatives to chemical preservatives for fish and fisheries products: A review. Food Control 2021, 129, 108244. [Google Scholar] [CrossRef]
- Chawla, R.; Sivakumar, S.; Kaur, H. Antimicrobial edible films in food packaging: Current scenario and recent nanotechnological advancements—A review. Carbohydr. Polym. Technol. Appl. 2021, 2, 100024. [Google Scholar] [CrossRef]
- Zemljič, L.F.; Tkavc, T.; Vesel, A.; Šauperl, O. Chitosan coatings onto polyethylene terephthalate for the development of potential active packaging material. Appl. Surf. Sci. 2013, 265, 697–703. [Google Scholar] [CrossRef]
- Deepika, K.L.; Gaikwad, K.K. Carbon dots for food packaging applications. Sustain. Food Technol. 2023, 1, 185–199. [Google Scholar] [CrossRef]
- Fadiji, T.; Rashvand, M.; Daramola, M.O.; Iwarere, S.A. A Review on Antimicrobial Packaging for Extending the Shelf Life of Food. Processes 2023, 11, 590. [Google Scholar] [CrossRef]
- Channa, I.A.; Ashfaq, J.; Gilani, S.J.; Shah, A.A.; Chandio, A.D.; Jumah, M.N.b. UV Blocking and Oxygen Barrier Coatings Based on Polyvinyl Alcohol and Zinc Oxide Nanoparticles for Packaging Applications. Coatings 2022, 12, 897. [Google Scholar] [CrossRef]
- Dai, L.; Li, R.; Liang, Y.; Liu, Y.; Zhang, W.; Shi, S. Development of Pomegranate Peel Extract and Nano ZnO Co-Reinforced Polylactic Acid Film for Active Food Packaging. Membranes 2022, 12, 1108. [Google Scholar] [CrossRef]
- Charoensri, K.; Rodwihok, C.; Ko, S.H.; Wongratanaphisan, D.; Park, H.J. Enhanced antimicrobial and physical properties of poly (butylene adipate-co-terephthalate)/zinc oxide/reduced graphene oxide ternary nanocomposite films. Mater. Today Commun. 2021, 28, 102586. [Google Scholar] [CrossRef]
- Laorenza, Y.; Chonhenchob, V.; Bumbudsanpharoke, N.; Jittanit, W.; Sae-tan, S.; Rachtanapun, C.; Chanput, W.P.; Charoensiddhi, S.; Srisa, A.; Promhuad, K.; et al. Polymeric Packaging Applications for Seafood Products: Packaging-Deterioration Relevance, Technology and Trends. Polymers 2022, 14, 3706. [Google Scholar] [CrossRef]
- Zare, M.; Namratha, K.; Ilyas, S.; Sultana, A.; Hezam, A.; Surmeneva, M.A.; Surmenev, R.A.; Nayan, M.B.; Ramakrishna, S.; Mathur, S.; et al. Emerging Trends for ZnO Nanoparticles and Their Applications in Food Packaging. ACS Food Sci. Technol. 2022, 2, 763–781. [Google Scholar] [CrossRef]
- Rodwihok, C.; Suwannakeaw, M.; Charoensri, K.; Wongratanaphisan, D.; Woon Woo, S.; Kim, H.S. Alkali/zinc-activated fly ash nanocomposites for dye removal and antibacterial applications. Bioresour. Technol. 2021, 331, 125060. [Google Scholar] [CrossRef]
- Mahlaule-Glory, L.M.; Hintsho-Mbita, N.C. Green Derived Zinc Oxide (ZnO) for the Degradation of Dyes from Wastewater and Their Antimicrobial Activity: A Review. Catalysts 2022, 12, 833. [Google Scholar] [CrossRef]
- St.Clair, R.; Pappas, D.; Fletcher, C.; Sharmina, M. Resilient or environmentally friendly? Both are possible when seafood businesses prepare for long-term risks. J. Clean. Prod. 2023, 408, 137045. [Google Scholar] [CrossRef]
- Rojas, K.; Canales, D.; Amigo, N.; Montoille, L.; Cament, A.; Rivas, L.M.; Gil-Castell, O.; Reyes, P.; Ulloa, M.T.; Ribes-Greus, A.; et al. Effective antimicrobial materials based on low-density polyethylene (LDPE) with zinc oxide (ZnO) nanoparticles. Compos. Part B Eng. 2019, 172, 173–178. [Google Scholar] [CrossRef]
- Huang, X.; Zhou, X.; Dai, Q.; Qin, Z. Antibacterial, Antioxidation, UV-Blocking, and Biodegradable Soy Protein Isolate Food Packaging Film with Mangosteen Peel Extract and ZnO Nanoparticles. Nanomaterials 2021, 11, 3337. [Google Scholar] [CrossRef]
- Kim, I.; Viswanathan, K.; Kasi, G.; Sadeghi, K.; Thanakkasaranee, S.; Seo, J. Poly(Lactic Acid)/ZnO Bionanocomposite Films with Positively Charged ZnO as Potential Antimicrobial Food Packaging Materials. Polymers 2019, 11, 1427. [Google Scholar] [CrossRef]
- Babaei-Ghazvini, A.; Shahabi-Ghahfarrokhi, I.; Goudarzi, V. Preparation of UV-protective starch/kefiran/ZnO nanocomposite as a packaging film: Characterization. Food Packag. Shelf Life 2018, 16, 103–111. [Google Scholar] [CrossRef]
- Rodwihok, C.; Charoensri, K.; Wongratanaphisan, D.; Choi, W.M.; Hur, S.H.; Park, H.J.; Chung, J.S. Improved photocatalytic activity of surface charge functionalized ZnO nanoparticles using aniline. J. Mater. Sci. Technol. 2021, 76, 1–10. [Google Scholar] [CrossRef]
- Jiang, Y.; Sun, L.; Jiang, F.; Xie, C.; Hu, L.; Dong, X.; Qin, F.; Liu, T.; Hu, L.; Jiang, X.; et al. Photocatalytic effect of ZnO on the stability of nonfullerene acceptors and its mitigation by SnO2 for nonfullerene organic solar cells. Mater. Horiz. 2019, 6, 1438–1443. [Google Scholar] [CrossRef]
- Khrenov, V.; Klapper, M.; Koch, M.; Müllen, K. Surface Functionalized ZnO Particles Designed for the Use in Transparent Nanocomposites. Macromol. Chem. Phys. 2005, 206, 95–101. [Google Scholar] [CrossRef]
- Charoensri, K.; Rodwihok, C.; Wongratanaphisan, D.; Ko, J.A.; Chung, J.S.; Park, H.J. Investigation of Functionalized Surface Charges of Thermoplastic Starch/Zinc Oxide Nanocomposite Films Using Polyaniline: The Potential of Improved Antibacterial Properties. Polymers 2021, 13, 425. [Google Scholar] [CrossRef] [PubMed]
- Charoensri, K.; Shin, Y.J.; Kim, K.C.; Park, H.J. Active Packaging Material Based on Immobilized Diatomaceous Earth/Zinc Oxide/High-Density Polyethylene Composite for Sea Food and Products. Polymers 2022, 14, 5228. [Google Scholar] [CrossRef]
- Grommersch, B.M.; Pant, J.; Hopkins, S.P.; Goudie, M.J.; Handa, H. Biotemplated synthesis and characterization of mesoporous nitric oxide-releasing diatomaceous earth silica particles. ACS Appl. Mater. Interfaces 2018, 10, 2291–2301. [Google Scholar] [CrossRef] [PubMed]
- Ruíz-Baltazar, Á.d.J. Green composite based on silver nanoparticles supported on diatomaceous earth: Kinetic adsorption models and antibacterial effect. J. Clust. Sci. 2018, 29, 509–519. [Google Scholar] [CrossRef]
- Fernández, M.A.; Bellotti, N. Silica-based bioactive solids obtained from modified diatomaceous earth to be used as antimicrobial filler material. Mater. Lett. 2017, 194, 130–134. [Google Scholar] [CrossRef]
- Germen, O. Investigation of Different UV Stabilizer Effects on HDPE Grades. Master’s Thesis, Izmir Institute of Technology, Urla, Türkiye, 2019. [Google Scholar]
- Christmann, J.; Gardette, J.-L.; Pichon, G.; Bouchut, B.; Therias, S. Photostabilization of polyethylene by a hindered amine light stabilizer in blooming conditions and impact of MDO processing. Polym. Degrad. Stab. 2021, 191, 109683. [Google Scholar] [CrossRef]
- ASTM D746-20; Standard Test Method for Brittleness Temperature of Plastics and Elastomers by Impact. ASTM Int.: West Conshohocken, PA, USA, 2020.
- ASTM D648; Standard Test Method for Deflection Temperature of Plastics Under Flexural Load in the Edgewise Position. ASTM Int.: West Conshohocken, PA, USA, 2018.
- ASTM G155-21; Standard Practice for Operating Xenon Arc Lamp Apparatus for Exposure of Materials. ASTM Int.: West Conshohocken, PA, USA, 2023.
- ASTM D256; Standard Test Methods for Determining the Izod Pendulum Impact Resistance of Plastics. ASTM Int.: West Conshohocken, PA, USA, 2023.
- ASTM E2149-20; Standard Test Method for Determining the Antimicrobial Activity of Antimicrobial Agents Under Dynamic Contact Conditions. ASTM Int.: West Conshohocken, PA, USA, 2020.
- JIS Z 2801: 2000; 8S. Test for Antimicrobial Activity of Plastics. Antimicrobial Products. Japanese Industrial Standard Committee: Tokyo, Japan, 2000.
- Liu, Z.; Sun, X.; Qin, X.; Yin, Y. Micro-analysis of the fusion process between light stabilizer and asphalt using different characterizing methods. Constr. Build. Mater. 2021, 287, 123045. [Google Scholar] [CrossRef]
- Liu, N.; Li, Y.; Xie, D.; Zeng, Q.; Xu, H.; Ge, M.; Zhang, W.; Zhang, Y.; Liu, R.; Dai, J.; et al. UV stabilizer intercalated layered double hydroxide to enhance the thermal and UV degradation resistance of polypropylene fiber. Polym. Test. 2023, 121, 107979. [Google Scholar] [CrossRef]
- Sun, X.; Yuan, J.; Liu, Z.; Qin, X.; Yin, Y. Evaluation and characterization on the segregation and dispersion of anti-UV aging modifying agent in asphalt binder. Constr. Build. Mater. 2021, 289, 123204. [Google Scholar] [CrossRef]
- Salakhov, I.I.; Shaidullin, N.M.; Chalykh, A.E.; Matsko, M.A.; Shapagin, A.V.; Batyrshin, A.Z.; Shandryuk, G.A.; Nifant’ev, I.E. Low-Temperature Mechanical Properties of High-Density and Low-Density Polyethylene and Their Blends. Polymers 2021, 13, 1821. [Google Scholar] [CrossRef] [PubMed]
- Alsayed, Z.; Awad, R.; Badawi, M.S. Thermo-mechanical properties of high density polyethylene with zinc oxide as a filler. Iran. Polym. J. 2020, 29, 309–320. [Google Scholar] [CrossRef]
- Li, S.-C.; Li, Y.-N. Mechanical and antibacterial properties of modified nano-ZnO/high-density polyethylene composite films with a low doped content of nano-ZnO. J. Appl. Polym. Sci. 2010, 116, 2965–2969. [Google Scholar] [CrossRef]
- Mahmoud, M.E.; Khalifa, M.A.; Youssef, M.R.; El-Sharkawy, R.M. Influence of MgO and ZnO as nano-additives on the mechanical, microstructural and thermal performance of high-density polyethylene. J. Appl. Polym. Sci. 2022, 139, e52705. [Google Scholar] [CrossRef]
- Tábi, T.; Ageyeva, T.; Kovács, J.G. Improving the ductility and heat deflection temperature of injection molded Poly(lactic acid) products: A comprehensive review. Polym. Test. 2021, 101, 107282. [Google Scholar] [CrossRef]
- Raja, T.; Devarajan, Y. A novel way of converting waste-enriched composites to lightweight, biodegradable resources: A property analysis. Biomass Convers. Biorefinery 2023. [Google Scholar] [CrossRef]
- Wang, J.; Tsou, A.H.; Passino, H.L.; Favis, B.D. PPE-g-HDPE in high-performance poly(p-phenylene ether)/polyethylene blends: Synthesis and compatibilization effects. Polymer 2018, 138, 92–102. [Google Scholar] [CrossRef]
- Kim, H.J.; Lee, J.J.; Kim, J.-C.; Kim, Y.C. Effect of starch content on the non-isothermal crystallization behavior of HDPE/silicate nanocomposites. J. Ind. Eng. Chem. 2010, 16, 406–410. [Google Scholar] [CrossRef]
- Behera, K.; Chiu, F.-C. Evident improvements in the rigidity, toughness, and electrical conductivity of PVDF/HDPE blend with selectively localized carbon nanotube. Polym. Test. 2020, 90, 106736. [Google Scholar] [CrossRef]
- Lee, D.; Kim, S.; Kim, B.-J.; Chun, S.-J.; Lee, S.-Y.; Wu, Q. Effect of Nano-CaCO3 and Talc on Property and Weathering Performance of PP Composites. Int. J. Polym. Sci. 2017, 2017, 4512378. [Google Scholar] [CrossRef]
- Koriem, A.; Ollick, A.M.; Elhadary, M. The effect of artificial weathering and hardening on mechanical properties of HDPE with and without UV stabilizers. Alex. Eng. J. 2021, 60, 4167–4175. [Google Scholar] [CrossRef]
- Sahu, A.K.; Sudhakar, K. Effect of UV exposure on bimodal HDPE floats for floating solar application. J. Mater. Res. Technol. 2019, 8, 147–156. [Google Scholar] [CrossRef]
- Tiwari, V.; Mishra, N.; Gadani, K.; Solanki, P.S.; Shah, N.A.; Tiwari, M. Mechanism of anti-bacterial activity of zinc oxide nanoparticle against carbapenem-resistant Acinetobacter baumannii. Front. Microbiol. 2018, 9, 1218. [Google Scholar] [CrossRef]
- Mendes, C.R.; Dilarri, G.; Forsan, C.F.; Sapata, V.d.M.R.; Lopes, P.R.M.; de Moraes, P.B.; Montagnolli, R.N.; Ferreira, H.; Bidoia, E.D. Antibacterial action and target mechanisms of zinc oxide nanoparticles against bacterial pathogens. Sci. Rep. 2022, 12, 2658. [Google Scholar] [CrossRef]
- Mulla, M.; Ahmed, J.; Al-Attar, H.; Castro-Aguirre, E.; Arfat, Y.A.; Auras, R. Antimicrobial efficacy of clove essential oil infused into chemically modified LLDPE film for chicken meat packaging. Food Control 2017, 73, 663–671. [Google Scholar] [CrossRef]
- Amariei, G.; Valenzuela, L.; Iglesias-Juez, A.; Rosal, R.; Visa, M. ZnO-functionalized fly-ash based zeolite for ciprofloxacin antibiotic degradation and pathogen inactivation. J. Environ. Chem. Eng. 2022, 10, 107603. [Google Scholar] [CrossRef]
- Torres-Giner, S.; Torres, A.; Ferrándiz, M.; Fombuena, V.; Balart, R. Antimicrobial activity of metal cation-exchanged zeolites and their evaluation on injection-molded pieces of bio-based high-density polyethylene. J. Food Saf. 2017, 37, e12348. [Google Scholar] [CrossRef]
- Azizi-Lalabadi, M.; Ehsani, A.; Divband, B.; Alizadeh-Sani, M. Antimicrobial activity of Titanium dioxide and Zinc oxide nanoparticles supported in 4A zeolite and evaluation the morphological characteristic. Sci. Rep. 2019, 9, 17439. [Google Scholar] [CrossRef]

| Sample | Izod Impact (J/m) | Stability at Sub-Zero Temperature | Tensile Strength (MPa) | Elongation (%) | Elastic Modulus (MPa) | HDT (°C) | |
|---|---|---|---|---|---|---|---|
| −40 °C | −60 °C | ||||||
| HDPE | 53.45 1.09 b | 26.23 0.21 a | 53.14 4.32 a | 0.51 0.42 b | 75.40 1.53 b | ||
| HDPE/DZ | 163.15 3.28 a | 27.31 1.52 a | 48.19 1.75 b | 0.64 0.87 a | 82.64 1.34 a | ||
| HDPE/DZ/T500 | 164.43 5.12 a | 28.49 1.81 a | 47.61 1.98 b | 0.65 0.11 a | 81.45 0.89 a | ||
| HDPE/DZ/T1000 | 164.12 1.81 a | 28.15 1.09 a | 47.84 1.02 b | 0.65 0.21 a | 82.35 1.45 a | ||
| HDPE/DZ/T2000 | 164.71 2.53 a | 28.63 1.17 a | 47.13 0.98 b | 0.64 0.93 | 82.71 0.83 a | ||
| Sample | HDPE | HDPE/DZ | HDPE/DE/T500 | HDPE/DE/T1000 | HDPE/DE/T2000 |
|---|---|---|---|---|---|
| Antimicrobial Activity (%) | |||||
| S. aureus | 0.00 (log 0.0) | 99.80 (log 2.7) | 99.40 (log 2.2) | 99.38 (log 2.2) | 99.37 (log 2.2) |
| E. coli | 0.00 (log 0.0) | 99.85 (log 2.8) | 99.78 (log 2.7) | 99.78 (log 2.7) | 99.75 (log 2.6) |
| Sample (HDPE/DZ/T500) | Day 0 | Day 30 | Day 90 | Day 180 | Day 365 |
|---|---|---|---|---|---|
| Antimicrobial Activity (%) | |||||
| S. aureus | 99.40 (log 2.2) | 98.76 (log 1.90) | 98.59 (log 1.85) | 98.18 (log 1.74) | 90.68 (log 1.03) |
| E. coli | 99.78 (log 2.7) | 98.92 (log 1.97) | 98.15 (log 1.73) | 98.03 (log 1.71) | 89.81 (log 0.99) |
Disclaimer/Publisher’s Note: The statements, opinions and data contained in all publications are solely those of the individual author(s) and contributor(s) and not of MDPI and/or the editor(s). MDPI and/or the editor(s) disclaim responsibility for any injury to people or property resulting from any ideas, methods, instructions or products referred to in the content. |
© 2023 by the authors. Licensee MDPI, Basel, Switzerland. This article is an open access article distributed under the terms and conditions of the Creative Commons Attribution (CC BY) license (https://creativecommons.org/licenses/by/4.0/).
Share and Cite
Charoensri, K.; Shin, Y.J.; Park, H.J. Innovative HDPE Composites Enriched with UV Stabilizer and Diatomaceous Earth/Zinc Oxide for Enhanced Seafood Packaging and Antimicrobial Properties. Polymers 2023, 15, 4577. https://doi.org/10.3390/polym15234577
Charoensri K, Shin YJ, Park HJ. Innovative HDPE Composites Enriched with UV Stabilizer and Diatomaceous Earth/Zinc Oxide for Enhanced Seafood Packaging and Antimicrobial Properties. Polymers. 2023; 15(23):4577. https://doi.org/10.3390/polym15234577
Chicago/Turabian StyleCharoensri, Korakot, Yang J. Shin, and Hyun J. Park. 2023. "Innovative HDPE Composites Enriched with UV Stabilizer and Diatomaceous Earth/Zinc Oxide for Enhanced Seafood Packaging and Antimicrobial Properties" Polymers 15, no. 23: 4577. https://doi.org/10.3390/polym15234577
APA StyleCharoensri, K., Shin, Y. J., & Park, H. J. (2023). Innovative HDPE Composites Enriched with UV Stabilizer and Diatomaceous Earth/Zinc Oxide for Enhanced Seafood Packaging and Antimicrobial Properties. Polymers, 15(23), 4577. https://doi.org/10.3390/polym15234577
